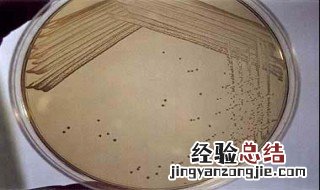
在平板划线法中为什么每次都要灼烧 平板划线每次划线前都要进行灼烧

【在平板划线法中为什么每次都要灼烧 平板划线每次划线前都要进行灼烧】
【在平板划线法中为什么每次都要灼烧 平板划线每次划线前都要进行灼烧】1、以免因菌过多而影响后面各区的分离效果 。
2、通过平板划线而获得微生物纯培养物的方法 , 又称平板划线法 。是指把混杂在一起的微生物或同一微生物群体中的不同细胞,用接种环在平板表面上作多次由点到线的划线稀释而获得较多独立分布的单个细胞 , 并让其成长为单菌落的方法 。通过反复划线分离,可获得微生物的纯种 。
3、通过划线分离后的某一平板培养物 。
经验总结扩展阅读
-
-
-
有一种“奶奶养娃”的说法 老一辈的人,往往比子女的父母更疼爱自己的孙子,这就是隔辈亲
-
体检 301斤猴哥体检结果不佳,高血压高血脂尿酸高,立志100天减50斤
-
-
-
-
-
自古以来在无数人的心目中 “冻龄姥姥”走红,27年前抱着闺女,现在抱着外孙女,却更漂亮
-
-
-
美白 21岁女大学生长期浓妆,素颜时满脸黄褐斑,医生:皮肤太伤了
-
-
-
-
心理学:你最喜欢下面哪套头饰,测你的“婚姻质量”怎么样?
-
-
-
-